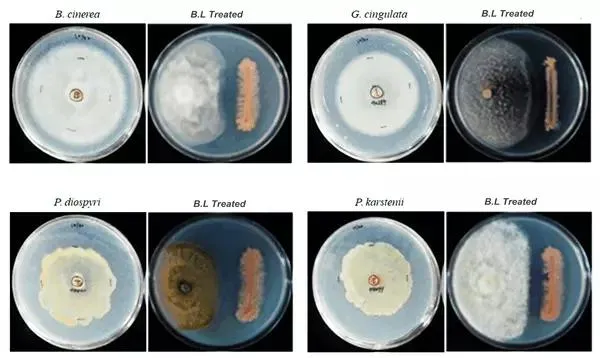
Bacillus Licheniformis Application

1 / 5










Introduction: Bacillus licheniformis is a soil-dwelling bacterium known for its ability to organic plant root stimulator and improve soil health in agriculture. It promotes crop growth through the production of compounds such as indole acetic acid, gibberellins, and cytokinins.
Antagonistic Activity: Biocontrols pathogenic fungal diseases including Botrytis Cinerea, Glomerella Cingulata, Pestalotia diospyri, and Pestalotiopsis karstenii.

Raddish root Control

Raddish root treated by B. licheniformis


